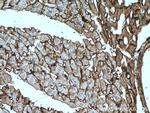
Dystroglycan Antibody in Immunohistochemistry (Paraffin) (IHC (P))

Search
Proteintech
Dystroglycan Monoclonal Antibody (2B1G12)
{{$productOrderCtrl.translations['antibody.pdp.commerceCard.promotion.promotions']}}
{{$productOrderCtrl.translations['antibody.pdp.commerceCard.promotion.viewpromo']}}
{{$productOrderCtrl.translations['antibody.pdp.commerceCard.promotion.promocode']}}: {{promo.promoCode}} {{promo.promoTitle}} {{promo.promoDescription}}. {{$productOrderCtrl.translations['antibody.pdp.commerceCard.promotion.learnmore']}}
产品信息
66735-1-IG
种属反应
宿主/亚型
分类
类型
克隆号
抗原
偶联物
形式
浓度
规格
纯化类型
保存液
内含物
保存条件
运输条件
产品详细信息
Immunogen sequence: VGEKSWVQF NSNSQLMYGL PDSSHVGKHE YFMHATDKGG LSAVDAFEIH VHRRPQGDRA PARFKAKFVG DPALVLNDIH KKIALVKKLA FAFGDRNCST ITLQNITRGS IVVEWTNNTL PLEPCPKEQI AGLSRRIAED DGKPRPAFSN ALEPDFKATS ITVTGSGSCR HLQFIPVVPP RRVPSEAPPT EVPDRDPEKS SEDDVYLHTV IPAVVVAAIL LIAGIIAMIC YRKKRKGKLT LEDQATFIKK GVPIIFADEL DDSKPPPSSS MPLILQEEKA PLPPPEYPNQ SVPETTPLNQ DTMGEYTPLR DEDPNAPPYQ PPPPFTAPME GKGSRPKNMT PYRSPPPYVP P (546-895 aa encoded by BC012740)
靶标信息
Dystroglycan is a laminin binding component of the dystrophin-glycoprotein complex which provides a linkage between the subsarcolemmal cytoskeleton and the extracellular matrix. Dystroglycan 1 is a candidate gene for the site of the mutation in autosomal recessive muscular dystrophies. The dramatic reduction of dystroglycan 1 in Duchenne muscular dystrophy leads to a loss of linkage between the sarcolemma and extracellular matrix, rendering muscle fibers more susceptible to necrosis. Dystroglycan also functions as dual receptor for agrin and laminin-2 in the Schwann cell membrane. The muscle and nonmuscle isoforms of dystroglycan differ by carbohydrate moieties but not protein sequence. Alternative splicing results in multiple transcript variants all encoding the same protein.
仅用于科研。不用于诊断过程。未经明确授权不得转售。
生物信息学
蛋白别名: alpha-dystroglycan; beta-dystroglycan; Dystroglycan; Dystroglycan 1; dystroglycan 1 (dystrophin-associated glycoprotein 1); dystrophin associated glycoprotein 1; Dystrophin-associated glycoprotein 1; unnamed protein product
基因别名: 156DAG; A3a; AGRNR; D9Wsu13e; DAG; DAG1; DG; Dp427; Dp71; LGMDR16; MDDGA9; MDDGC7; MDDGC9
UniProt ID: (Human) Q14118, (Mouse) Q62165
Entrez Gene ID: (Human) 1605, (Pig) 100620392, (Mouse) 13138, (Rat) 114489